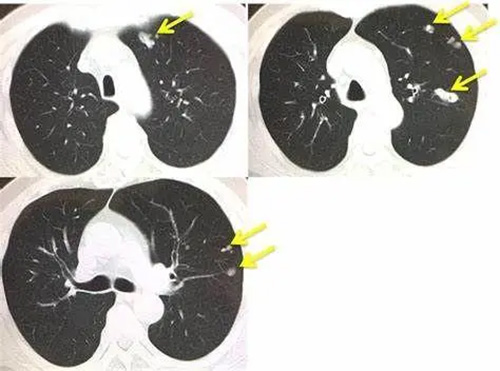
6-1.jpg

Release date: 2024-07-09 11:45:29 Article From: Lucius Laos Recommended: 551
Lung cancer is the most rapidly increasing malignant tumor with the fastest increasing morbidity and mortality, which has been troubling medical workers. Clinical studies have found that about 15% of non-small cell lung cancer (NSCLC) cells are driven by EGFR gene mutations. These EGFR-dependent cancer cells can be treated with EGFR inhibitors.
However, there are still some cancer cells that depend on the AXL gene for survival. These tumors have a greater ability to advance and can transition between sensitive and resistant states. After the end of treatment, the residual AXL-dependent tumor can recur and metastasize. This is also one of the important reasons why lung cancer is difficult to treat.

To this end, Lucius Pharmaceutical, Laos, has developed a new drug targeting the AXL gene, lorlatinib. This is a third-generation targeted drug for lung cancer.
A number of large international clinical studies have shown that lorlatinib has a good safety profile. It is specifically used in patients with advanced NSCLC after the emergence of ALK gene resistance, and its response rate can be as high as 46%. There was also a 42% remission effect in brain migration, with a median disease-free survival of nearly 10 months.

Lucius Pharmaceutical has long-term cooperation with tertiary hospitals in China to introduce lorlatinib into clinical application in China. Continuously optimize treatment options by monitoring patient responses in real time. It has also established a business network in the pan-Asian and Southeast Asian regions to provide more treatment options for cancer patients in Thailand, Japan, Australia and other countries and regions.
In the future, Lucius will further develop a new generation of targeted drugs and explore more therapeutic pathways for gene variants. We work closely with medical institutions to accelerate the process of efficacy verification and application, and ultimately help lung cancer patients improve their quality of life.
Dr. Louis, a microbiologist at the World Health Organization (WHO), recently made a technical visit to Lucius Pharmaceuticals in Laos. The purpose of the visit was to learn more ab···【more】
Recommended:621Release date: 2024-07-09
Lung cancer is the most rapidly increasing malignant tumor with the fastest increasing morbidity and mortality, which has been troubling medical workers. Clinical studies have foun···【more】
Recommended:552Release date: 2024-07-09
On November 21, 2025, the U.S. Food and Drug Administration (FDA) approved the regimen of pembrolizumab (Keytruda, Merck & Co., Inc.) or pembrolizumab and berahyaluronidase alf···【more】
Recommended:350Release date: 2025-12-17
On December 12, 2025, the U.S. Food and Drug Administration (FDA) approved niraparib in combination with abiraterone acetate (brand name: Akeega, Janssen Biotech, Inc.) plus predni···【more】
Recommended:336Release date: 2025-12-15
The U.S. Food and Drug Administration (FDA) announced today that it has approved Omisirge (omidubicel-onlv), the first hematopoietic stem cell transplantation (HSCT) therapy for th···【more】
Recommended:352Release date: 2025-12-10
On December 4, 2025, the U.S. Food and Drug Administration (FDA) approved lisocabtagene maraleucel (Breyanzi, developed by Juno Therapeutics, a subsidiary of Bristol Myers Squibb) ···【more】
Recommended:327Release date: 2025-12-08
On December 3, 2025, the U.S. Food and Drug Administration (FDA) granted full approval to pirtobrutinib (Jaypirca, Eli Lilly and Company) for the treatment of adult patients with r···【more】
Recommended:393Release date: 2025-12-04
Primary analysis data from the randomized, double-blind, placebo-controlled phase III HER2CLIMB-02 study showed that for patients with HER2-positive locally advanced or metastatic ···【more】
Recommended:326Release date: 2025-12-01
The Cure SMA Foundation, a global leading non-profit organization dedicated to spinal muscular atrophy (SMA), announced today its welcome for the U.S. Food and Drug Administration ···【more】
Recommended:301Release date: 2025-11-27
On November 14, 2024, the Committee for Medicinal Products for Human Use (CHMP) of the European Medicines Agency (EMA) issued favorable opinions, proposing an amendment to the mark···【more】
Recommended:571Release date: 2025-01-13
Recent advancements have reaffirmed the significance of liquid biopsy in the management of advanced solid tumors, although further prospective research is still required. Historica···【more】
Recommended:495Release date: 2025-01-06
FDA Approves First Generic Version of Victoza (liraglutide injection)The U.S. Food and Drug Administration (FDA) has given the green light to the first generic version of Victoza (···【more】
Recommended:563Release date: 2024-12-30
The new indication involves the treatment of adult patients with locally advanced, unresectable non-small cell lung cancer with tumors with EGFR exon 19 deletion or exon 21 (L858R)···【more】
Recommended:473Release date: 2024-12-24
he U.S. Food and Drug Administration (FDA) has approved Crenessity (crinecerfont) for use in combination with glucocorticoids (steroids) to help manage androgen (testosterone-like ···【more】
Recommended:510Release date: 2024-12-17
At a grand pharmaceutical exhibition held recently in Dubai, Lucius Company of Laos was in the spotlight for its outstanding performance. Their booth attracted a large audience and···【more】
Recommended:529Release date: 2024-07-09
On October 18-19, 2023, Dr. Luís Meirinhos Soares, a microbiology expert appointed by the World Health Organization (WHO) and director of the Microbiology Laboratory of the Nationa···【more】
Recommended:530Release date: 2024-07-09
On October 19, 2023, the World Health Organization (WHO) conducted a comprehensive inspection of the Lucius Pharmaceutical factory in Laos. The results of this assessment are encou···【more】
Recommended:597Release date: 2024-07-09
At present, the competition in all walks of life is very fierce, especially in the pharmaceutical industry, Lucius Pharmaceutical was established in Vientiane, Laos in 2020, with a···【more】
Recommended:469Release date: 2024-07-09
Here are some key points about Lucius Pharmaceutical:Lucius Pharmaceuticals has state-of-the-art facilities, including factories designed and constructed in strict accordance with ···【more】
Recommended:680Release date: 2024-07-09
From the Black Sea, the most terrifying ocean on earth, to the Mediterranean Sea, Lucius Pharmaceuticals stands on the only Turkish Strait that connects the two seas, announcing Lu···【more】
Recommended:472Release date: 2024-07-09
As we all know, from the perspective of the universe, our solar system is very small, but from the perspective of the earth, it is very huge, the edge of the solar system is the Oo···【more】
Recommended:466Release date: 2024-07-09
At the beginning of May, Lucius Pharmaceutical (Laos) Co., Ltd. officially obtained the approval of the Ministry of Health of the People's Republic of China and launched 8 prod···【more】
Recommended:478Release date: 2024-07-09
The BRAF inhibitor known as Braftovi, manufactured by the French company pierre Fabre.What is the price of Braftovi per box? Where can it be purchased?Currently, there are two main···【more】
Recommended:630Release date: 2024-07-08

Lucius Pharmaceutical Co., Ltd., was established in 2020 in Vientiane, the capital of Laos. It aims to offer safe, effective, and affordable medicines globally. With a factory spanning 25,000 square meters, the company manufactures 200+ generic drugs in diverse therapeutic fields.
Address: No.26 Thongmang village, Xaythany district, Vientiane Capital, Laos
E-mail:laoslucius@gmail.com

Name: Lucius

Telegram name: Vira
No.:0085253923643


Telegram name: Vira
No.:0085253923643